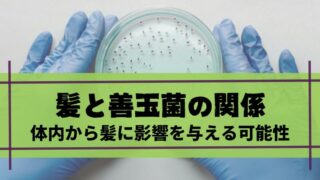

薄毛対策
薄毛対策 AGAと皮膚ターンオーバー
AGAと皮膚ターンオーバーの関係とは?頭皮環境の乱れが薄毛につながる理由をわかりやすく解説「最近、抜け毛が増えた気がする」「頭皮の乾燥やフケが気になる」と感じたとき、AGAや薄毛との関係を心配する方は少なくありません。髪そのものに注目しがち...
 薄毛対策
薄毛対策  薄毛対策
薄毛対策  薄毛対策
薄毛対策  薄毛対策
薄毛対策  薄毛対策
薄毛対策 薄毛対策
薄毛対策  薄毛対策
薄毛対策  薄毛対策
薄毛対策  薄毛対策
薄毛対策  薄毛対策
薄毛対策